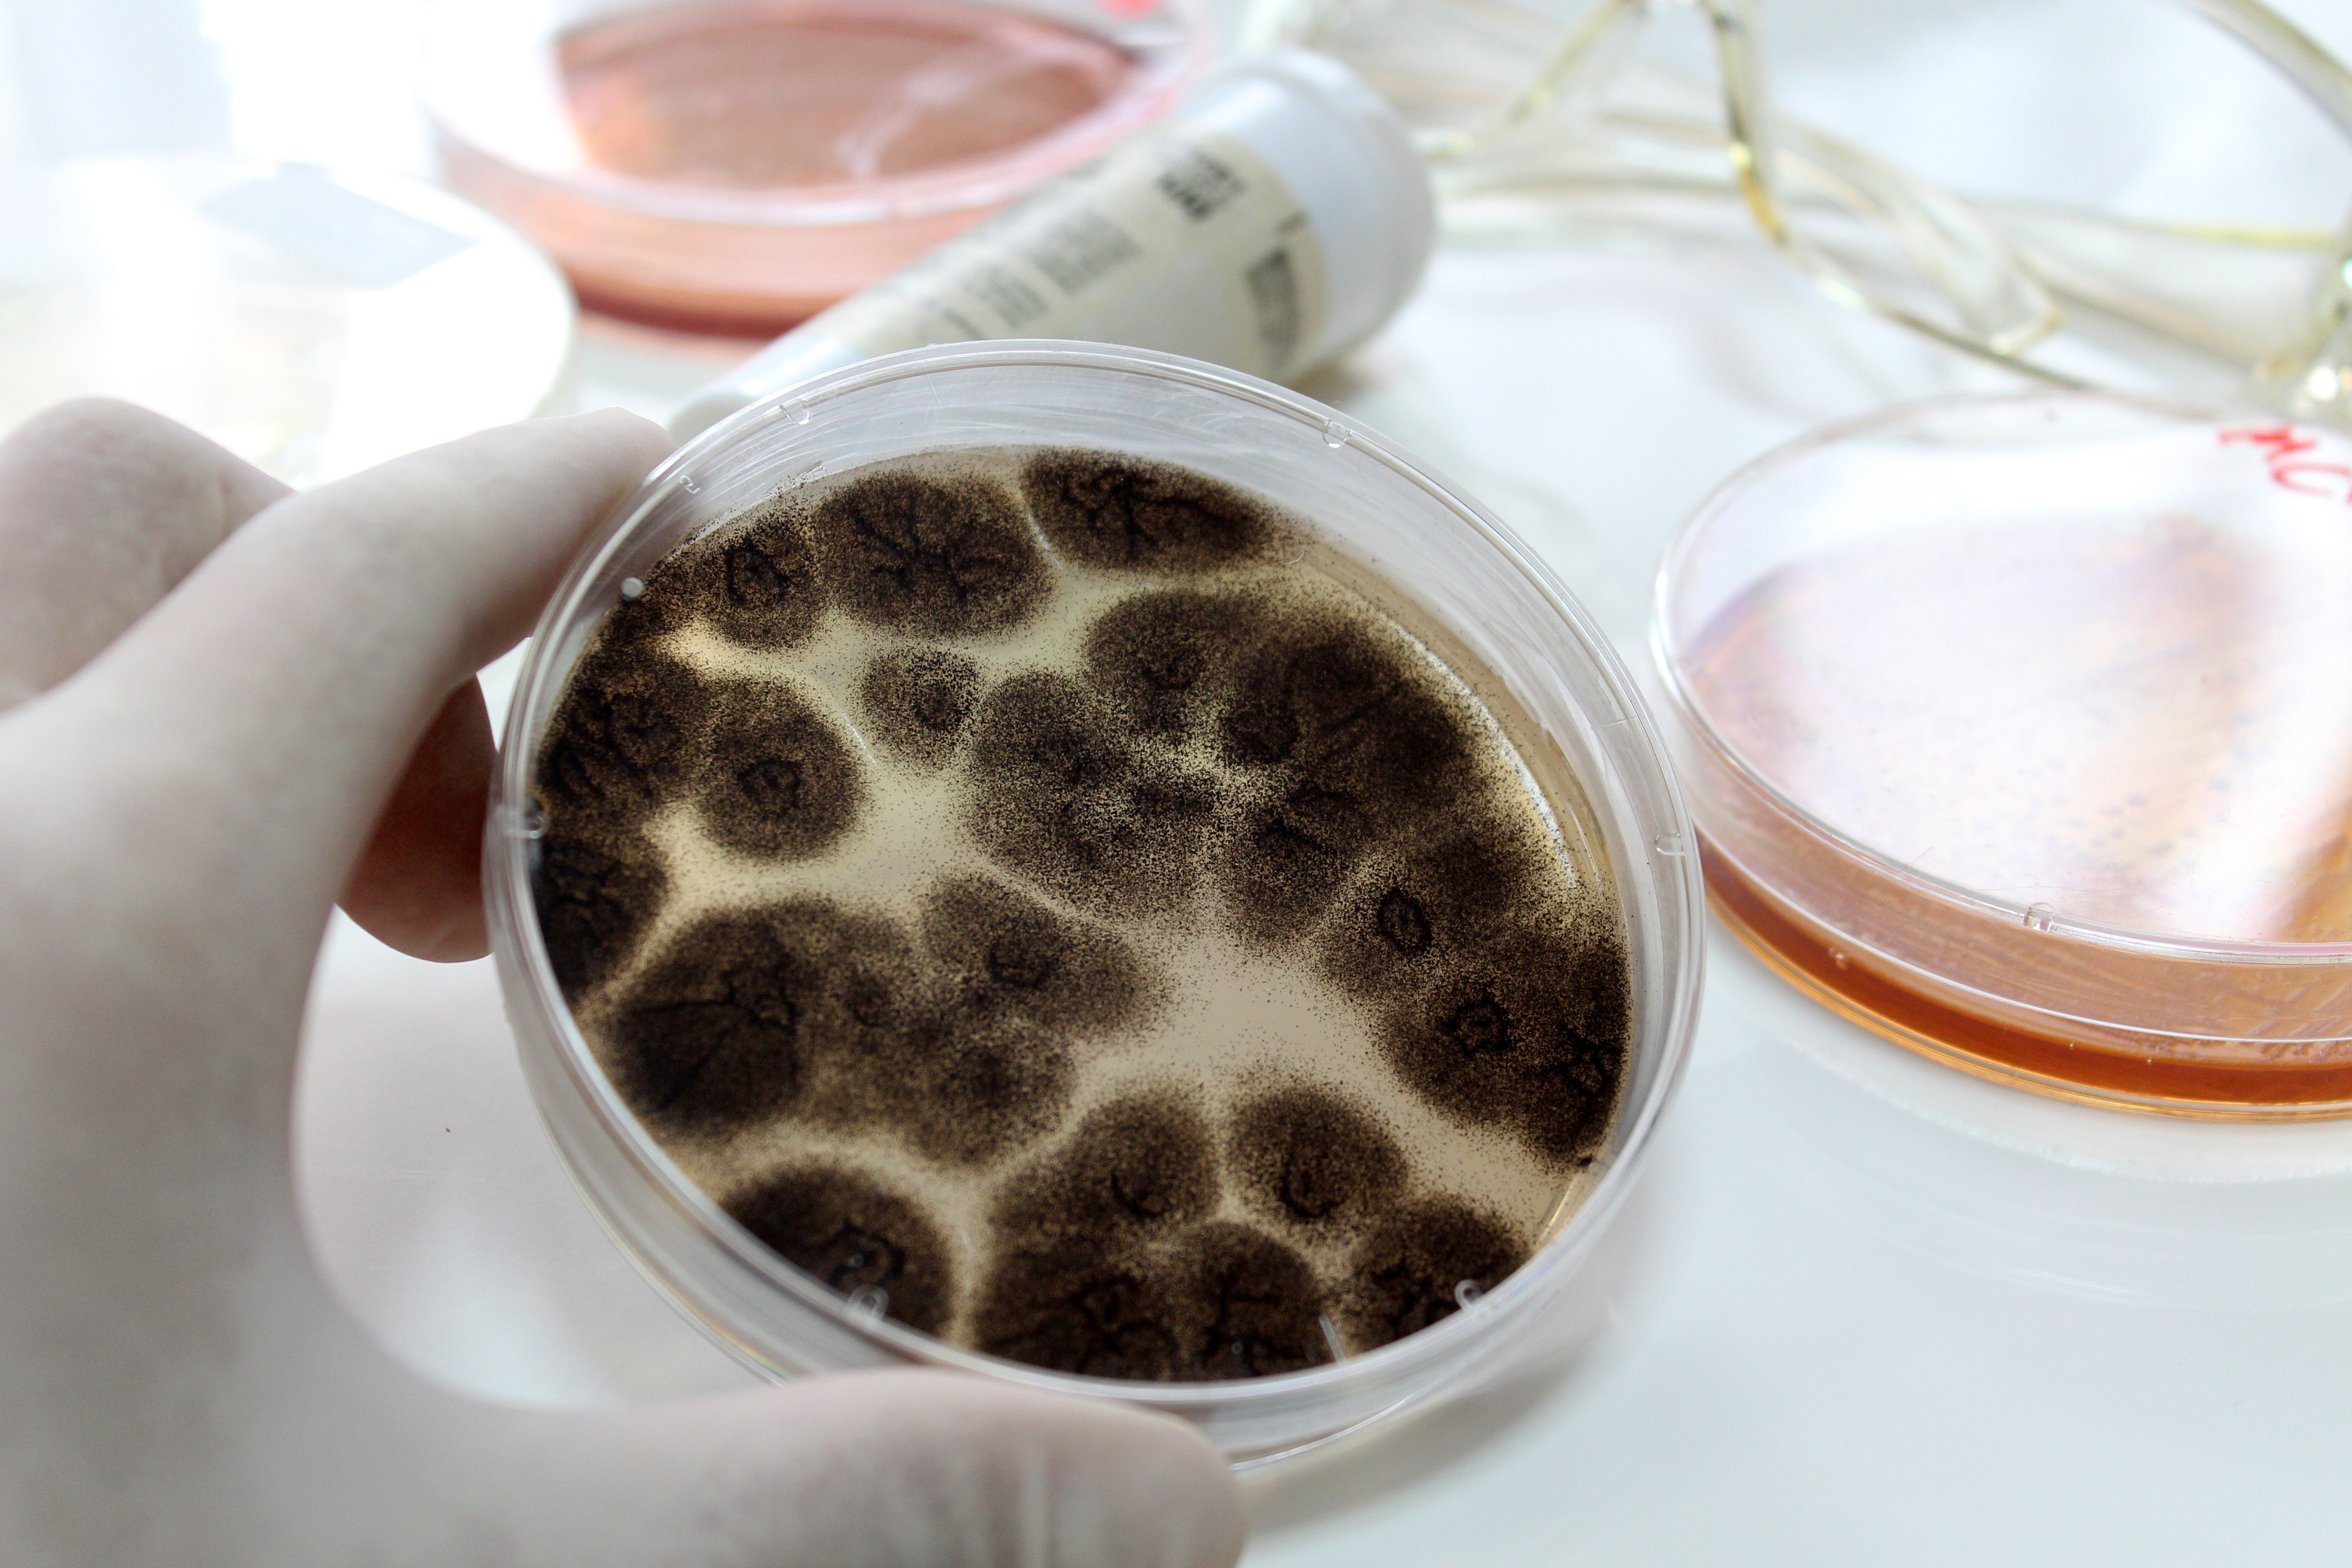
Adobe

Tag:
-
Grzybice układowe – niedoceniane zagrożenie
Według najnowszych badań inwazyjne grzybice mogą odpowiadać nawet za 3,8 miliona zgonów rocznie na świecie. Jeszcze niedawno uznawano je za choroby rzadkie i marginalne, „przywleczone z tropików” - dziś coraz częściej pojawiają się w szpitalach, gdzie atakują pacjentów z osłabioną odpornością.
NAJNOWSZE
-

Kompulsja: uwięzieni w nawyku
Myjemy ręce po raz kolejny, sprawdzamy zamki w drzwiach jeszcze raz, liczymy w myślach do „bezpiecznej” liczby. Dla jednych to drobny nawyk, dla innych – codzienny przymus, który przejmuje kontrolę nad życiem. Czym naprawdę jest kompulsja i skąd się bierze?
-
Upały są obciążeniem dla serca
-
Czy pojęcie mniejszość seksualna jest pojęciem adekwatnym?
-
Sport, pasja i zdrowie. Startuje turniej dla dzieci z cukrzycą
-
Etykieta to „dowód tożsamości” produktu. Zdrowo wiedzieć, co kryje w sobie
